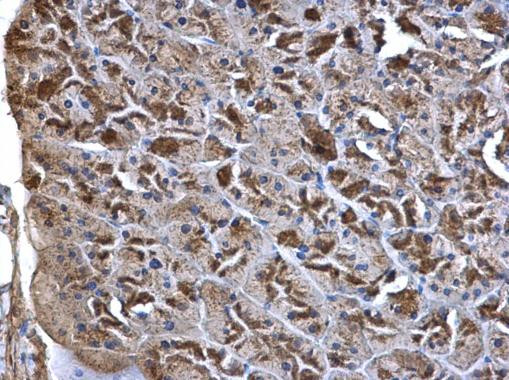
WNT7A Antibody in Immunohistochemistry (Paraffin) (IHC (P))

Search
Invitrogen
WNT7A Polyclonal Antibody
{{$productOrderCtrl.translations['antibody.pdp.commerceCard.promotion.promotions']}}
{{$productOrderCtrl.translations['antibody.pdp.commerceCard.promotion.viewpromo']}}
{{$productOrderCtrl.translations['antibody.pdp.commerceCard.promotion.promocode']}}: {{promo.promoCode}} {{promo.promoTitle}} {{promo.promoDescription}}. {{$productOrderCtrl.translations['antibody.pdp.commerceCard.promotion.learnmore']}}



Please note: We are reviewing Western blot images included in the antibody testing data in our catalog, including those provided by third parties. Unless expressly labeled or annotated as “raw-unedited”, Western blot images included in the antibody testing data in our catalog may have been edited, optimized or otherwise adjusted for presentation.
产品信息
PA5-28289
种属反应
宿主/亚型
分类
类型
抗原
偶联物
形式
浓度
规格
纯化类型
保存液
内含物
保存条件
运输条件
RRID
产品详细信息
Recommended positive controls: WNT7A-transfected 293T.
Predicted reactivity: Mouse (100%), Rat (100%), Chicken (96%), Rhesus Monkey (100%), Bovine (100%).
Store product as a concentrated solution. Centrifuge briefly prior to opening the vial.
靶标信息
Wnt-7a belongs to the Wnt family of signaling proteins that play a key role in maintaining the integrity of embryonic and adult tissues. It is expressed in placenta, kidney, testis, uterus, fetal lung, and fetal and adult brain. Most Wnt proteins can signal though a mechanism called the canonical Wnt pathway, in which Wnt proteins bind to and activate seven-pass transmembrane receptors of the Frizzled family, ultimately leading to the disruption of β-catenin degradation. Intracellular accumulation of β-catenin increases translocation of the protein into the nucleus, where it binds to TCF/LEF transcription factors to induce the expression of numerous genes. Increased Wnt/β-catenin signaling is associated with tumorigenesis in a diverse set of human cancers. However, Wnt-7a/Frizzled-9 signaling has been shown to act as a tumor suppressor in non-small cell lung cancers.
仅用于科研。不用于诊断过程。未经明确授权不得转售。
篇参考文献 (0)
生物信息学
蛋白别名: postaxial hemimelia; Protein Wnt-7a; wingless-related MMTV integration site 7A
基因别名: AI849442; px; tw; Wnt-7a; WNT7A
UniProt ID: (Mouse) P24383
Entrez Gene ID: (Mouse) 22421